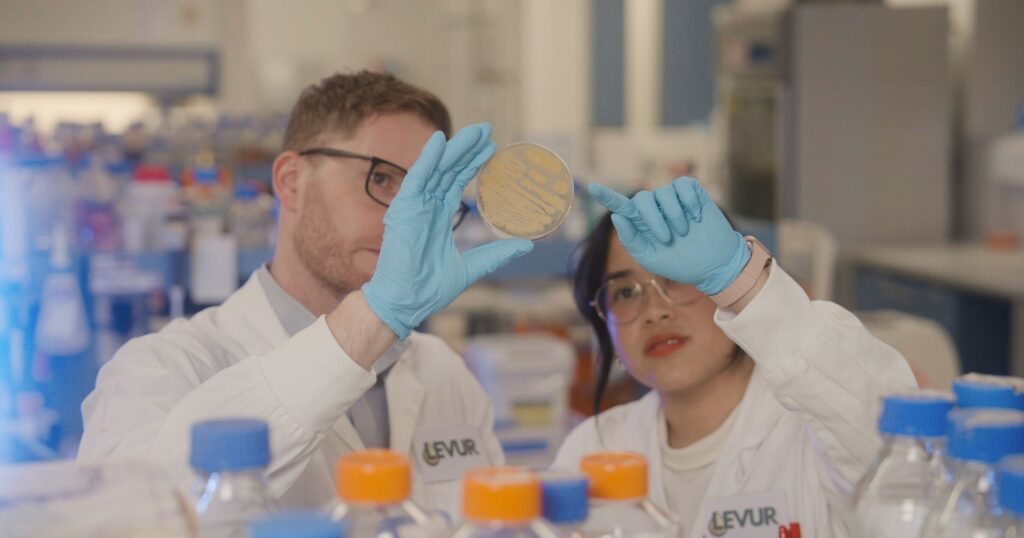
Future Food Quick Bites: Cultivated Pet Food, Khloe Kardashian & Nutella Peanut

The landscape of sustainable food innovation continues to evolve at a rapid pace, with a consistent stream of new products, company updates, and policy developments shaping the industry. This week’s Future Food Quick Bites highlights a diverse range of advancements, from the groundbreaking entry of cultivated pet food into the Singapore market to the strategic expansion of plant-based offerings by established brands and the ongoing regulatory discussions surrounding alternative proteins.
Cultivated Pet Food Makes its Singapore Debut

In a significant move for the alternative protein sector, U.S. startup Friends & Family Pet Food Co. has successfully launched its first cultivated pet food products in Singapore. The company debuted its Kampung bird-flavored cultivated meat treats at the Singapore Pet Expo, held from April 3rd to 5th. The initial reception was overwhelmingly positive, with approximately 200 packs sold, representing an estimated 18 kilograms of fresh cultivated meat. Crucially, the treats achieved an impressive 82% acceptance rate among canine and feline testers, a key metric for consumer product success in the pet food industry. This strong performance signals a promising future for cultivated meat in the companion animal market. The company is now preparing for a full retail launch next month, aiming to bring this novel protein source to a wider audience.
The development of cultivated meat for pets addresses a growing concern among pet owners regarding the environmental and ethical impact of traditional meat production. By offering a product that bypasses conventional animal agriculture, Friends & Family Pet Food Co. is tapping into a market segment increasingly driven by sustainability values. The successful trial in Singapore, a city-state known for its forward-thinking approach to food technology and regulation, also positions the company for potential expansion into other Asian markets. Industry analysts suggest that the pet food sector, with its inherent focus on animal well-being, could become an early adopter of cultivated meat technologies, potentially paving the way for broader consumer acceptance in the future.
Celebrity Ventures into Plant-Based Snacks and Dairy-Free Innovations

The trend of celebrity involvement in the sustainable food space continues, with Khloe Kardashian launching her new snack brand, Khloud. The brand has introduced a line of nacho chips infused with pea protein. Notably, two of the initial flavors, Buffalo and Sweet Heat, are entirely dairy-free, catering to a growing demand for plant-based snack options. These chips are exclusively available at Target and retail for $6.99 per 5oz pack, offering 7 grams of protein per 30-gram serving. This launch underscores the continued mainstreaming of plant-based ingredients in everyday consumer products, driven by both health consciousness and ethical considerations.
Meanwhile, global confectionery giant Ferrero has expanded its plant-based offerings with the introduction of Nutella Peanut in the U.S. This new spread, based on peanuts and formulated with a vegan recipe, marks the first plant-based iteration of the iconic Nutella to be released in the American market. It is currently available through Walmart and Amazon. A dairy-free version of the classic hazelnut spread has been available in several European countries since 2024, indicating a strategic global push towards diversifying the Nutella portfolio to meet evolving consumer preferences for plant-based alternatives. The move by a legacy brand like Ferrero signifies a significant shift in the market, demonstrating that even traditional product categories are embracing sustainable ingredient innovations.
Dairy-Free Brands Launch Engaging Marketing Campaigns and New Products

The dairy-free sector is also witnessing robust activity, with several brands employing creative strategies to capture consumer attention. Planet Oat, a prominent oat milk brand, has launched "The Great Coffee Debate Sweepstakes," featuring celebrity endorsements from actors Rebel Wilson and Adam Devine. The campaign encourages consumers to choose between their preferred coffee preparation – iced or hot. The sweepstakes offers attractive prizes, including two at-home coffee setups tailored to the winners’ preferences, and 100 coupons for a free carton of Planet Oat oat milk. Such engaging campaigns are crucial for building brand loyalty and driving trial in a competitive market.
Danone-owned Silk, a well-established non-dairy brand, has introduced a new marketing campaign in Canada for its protein-boosted milk. Developed in collaboration with Havas Creative Canada, WPP Media, and Edelman, the campaign features the tagline "I Got the Plant Power." This initiative aims to highlight the nutritional benefits and empowering nature of plant-based alternatives. Concurrently, Whole Moon has launched a promotional campaign called "Straight Up Good." This campaign features three 30-second advertisements that showcase individuals enjoying their clean-label milks directly, emphasizing the purity and inherent quality of the product without the need for additional ingredients or preparations. These campaigns collectively reflect a growing emphasis on the direct consumption and inherent benefits of plant-based dairy alternatives.
Data Platforms and Ingredient Innovations Drive the Protein Transition

Beyond consumer-facing products, the infrastructure supporting the protein transition is also expanding. U.S. data platform Livvie has unveiled Livvie Business, an impact calculator designed for organizations transitioning to more plant-based offerings and advocating for the broader protein transition. This software utilizes simple operational inputs, such as meals served or weight distributed, to quantify outcomes across 22 key parameters, including environmental impact, animal welfare, and public health. Such tools are vital for businesses seeking to measure and communicate the tangible benefits of their sustainability initiatives, providing data-driven insights to support strategic decision-making and stakeholder engagement.
In the realm of ingredient innovation, Ardent Mills, a U.S. company, has introduced Dark Cocoa Replace to its portfolio of wheat-based cocoa substitutes. This innovative ingredient can replace up to 90% of highly alkalized dark cocoa powders in a wide range of applications, including cakes, muffins, cookies, and bread. This development offers a more sustainable and potentially cost-effective alternative for manufacturers looking to reduce their reliance on traditional cocoa, which can be subject to supply chain volatility and environmental concerns.
Furthering technological advancements in the cultivated meat sector, Tufts University spinout Deco Labs has launched cAlbumin. This plant-derived substitute for albumin in animal cell culture media addresses a critical bottleneck in the production of cultivated meat. Albumin is a key component in cell culture media, essential for cell growth and viability. By providing a plant-based alternative, Deco Labs aims to streamline the production process and potentially reduce costs associated with cultivated meat manufacturing, bringing the technology closer to commercial viability.

European Market Sees Plant-Based Expansion and Regulatory Scrutiny
The European market is a focal point for plant-based innovation and regulatory developments. In France, Burger King has integrated King Tortillas into its menu, offering vegetarian options that utilize La Vie’s plant-based bacon. This collaboration highlights the increasing availability and acceptance of plant-based ingredients in fast-food chains across Europe. Nxtfood, a French plant-based meat manufacturer, has also expanded its reach, rolling out 11 products from its Accro brand in Intermarché stores across Belgium. This expansion signifies a growing demand for plant-based meat alternatives in the Belgian retail landscape.
In the United Kingdom, Minor Figures, a British plant-based milk company, is broadening its product line beyond its core oat milk offerings. The company has launched a barista almond milk in Australia, formulated with 3.5% almonds, sugar, and olive oil, alongside stabilizers and emulsifiers. This move into almond milk demonstrates a strategic effort to diversify its portfolio and cater to a wider range of consumer preferences within the plant-based beverage market.

Slovenian whole-cut plant-based meat producer Juicy Marbles has seen its Thick-Cut Filet and Baby Ribs featured in a four-day promotion at Lidl stores in Croatia. This collaboration with a major European retailer underscores the growing presence of innovative plant-based meats in mainstream grocery channels.
The beanless coffee startup Prefer, based in Singapore, has entered into a commercial partnership with juice vending machine provider iJooz. This collaboration will see Prefer’s iced dairy and oat lattes available across 30 iJooz machines for a month-long trial, expanding access to alternative coffee beverages through innovative distribution channels.
Company and Finance Updates Reflect Market Growth and Strategic Shifts

The financial and strategic movements within the food innovation sector provide insights into market trends. French plant-based meat leader HappyVore has reported a record quarter for the first three months of 2026, capturing a significant 21% market share in its domestic market. This positions HappyVore as a dominant player, outpacing its closest competitor, Garden Gourmet, by three percentage points.
Australian precision fermentation startup All G has appointed Carlos Andrés Martínez Cristancho as its head of biomanufacturing. With 13 years of experience at Evonik, a chemical manufacturing company, Cristancho’s expertise is expected to bolster All G’s capabilities in scaling its precision fermentation processes for producing alternative proteins.
In response to Switzerland’s recent ban on plant-based meat labels, local vegan company Planted has adjusted its product descriptors. The term "chicken" is no longer used as a primary descriptor, instead appearing in a smaller tagline, "Cook it like chicken," indicating a strategic adaptation to evolving regulatory landscapes.
UK company Heck, known for its dual meat and plant-based sausage offerings, is reportedly considering a move into the cultivated meat space. The company has re-entered discussions with Oxford-based startup Ivy Farm Technologies, signaling a potential diversification into this emerging field.
Data from UK meal kit company HelloFresh reveals a nuanced shift in consumer dietary habits. While orders for vegetarian recipes declined by 7% over the past year, the selection of meat-free meals increased by 29%. This suggests a growing flexitarian trend, where consumers are reducing meat consumption rather than adopting strict vegetarianism. Currently, half of UK adults identify as flexitarian, with a notable portion transitioning away from previous vegetarian diets.
Aussie precision fermentation startup Levur has received a substantial A$250,000 grant from the Department of Industry, Science and Resources’ Industry Growth Program. This funding will be used to refine Levur’s technology for producing sustainable palm oil alternatives for various applications, including food, cosmetics, and nutraceuticals, highlighting a focus on sustainable ingredient sourcing.

Research and Policy Developments Shape the Future of Food
Regulatory and research developments continue to shape the broader context for food innovation. The European Parliament’s agriculture committee has voted in favor of changes to the EU’s Common Market Organisation, which would prohibit the use of 31 meat-related terms on plant-based product packaging. This legislation, approved by co-legislators in March, now awaits a final plenary vote in the Parliament, potentially impacting how plant-based products are marketed across the EU.
Following an update to national dietary guidelines last year, the Netherlands Nutrition Centre has formalized its recommendations with a new "Wheel of Five." This dietary framework encourages reduced consumption of meat and cheese and promotes increased intake of plant-based foods, reflecting a growing public health emphasis on sustainable and healthy eating patterns.

China has launched its first nationwide agriculture climate resource survey in over four decades. Conducted by the China Meteorological Administration, the four-year survey will assess 25 crops and aims to update climate zoning for various agricultural sectors in response to increasing disaster risks faced by farmers. This initiative underscores a commitment to climate resilience and sustainable agricultural practices in the world’s second-largest economy.
The International Institute for Environment and Development has unveiled a comprehensive Food Security Index covering 162 countries. The index ranks Iceland highest and Somalia lowest, providing a global benchmark for food security and highlighting regional disparities. Such indices are critical for identifying areas requiring targeted intervention and policy development.
In recognition of its innovative approach, bean-free coffee and chocolate maker Prefer has been named in Forbes Asia’s 100 To Watch, Class of 2025 list, underscoring its potential for future growth and impact.

Finally, British startup Potina, known for its kid-friendly banana oat milk, has been selected for this year’s Tesco Accelerator program. This prestigious program offers support and mentorship to promising startups, signaling a potential for broader market penetration for Potina’s unique product offerings.
The ongoing stream of product launches, strategic investments, and policy discussions indicates a dynamic and rapidly evolving sustainable food sector. From cultivated meats to plant-based alternatives and innovative ingredients, the industry is demonstrating a strong capacity for innovation and adaptation in response to global challenges and consumer demand.
